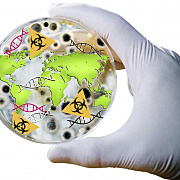
PROTOCOLO DE CARTAGENA

-
Establecimiento de Zonas Forestales Protectoras y Bosques de Interés General, para preservación de los recursos naturales renovables.
-
Acuerdo para el ingreso de animales silvestres al país para la repoblación de la fauna.
-
Acuerdo para la regularización del uso y explotación de la flora y fauna terrestre y acuática como manejo de recursos naturales.
-
Es la reacción a la creciente explotación del kril antártico, para preservación de la flora y fauna marina de la Antártida.
-
Conjunto de normas para convivencia y fortalecimiento de la nación y la ciudadanía.
-
Insta a estimular conciencia pública a nivel mundial sobre los problemas climáticos,
-
Establece medias concretas para eliminar sustancias que deterioren la capa de ozono y así preservar el medio ambiente y evitar años en la salud
-
Establece normas y procedimientos permitiendo de una manera segura la manipulación de los organismos vivos modificados por la biotecnología moderna.
-
Recolección de información del ministerio de Ambiente, Vivienda y Desarrollo Territorial a los gobernantes departamentales y municipales por afectación del fenómeno de la niña.
-
Se establece las directrices para gestión del cambio climático por cabezas administrativas como presidente, gobernadores y así sucesivamente,
Want to make a timeline like this?
Use Timetoast to turn dates, events, milestones, and phases into a clear visual timeline you can build and share. Timetoast is a timeline maker for work, school, research, and stories.